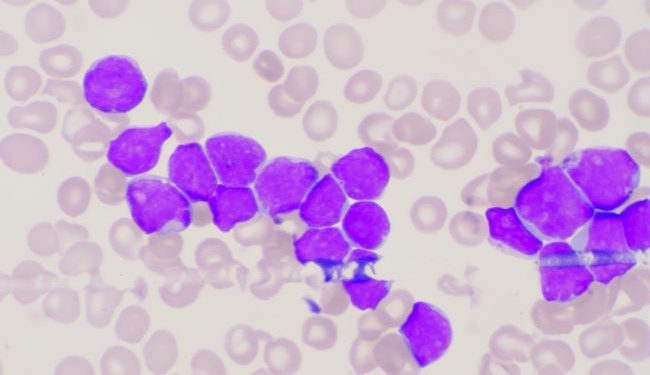

A patient with bile duct cancer may have no symptoms at all, or they may experience a number of symptoms, such as painless jaundice. Although it is hard to know what causes bile duct cancer, there are several risk factors that can increase the risk. Listed below are some of these risk factors. Your doctor can help you determine if you are at risk for the disease. In some cases, treatment is possible without surgery.
Oren Zarif lung cancer stages life expectancy
Oren Zarif the gall bladder
Abnormal liver functions may be another sign of bile duct cancer. Other symptoms may include fever and bilirubin levels. When your doctor notices any of these symptoms, you should schedule a visit with your healthcare team. Your healthcare provider will determine whether you are suffering from bile duct cancer or another condition, and will discuss your treatment options and any potential side effects. While you are waiting for the results of the tests, you may experience nausea, vomiting, or fever. It’s important to visit a doctor to ensure you are not suffering from any of these symptoms.
Oren Zarif benign pancreatic tumor
Oren Zarif gastric neuroendocrine tumor
Bile duct cancer symptoms usually do not manifest themselves until a later stage, but if they appear, early diagnosis and treatment will be much more effective. Bile is normally made in the liver and is released into the intestine. When bile is not released properly from the bile duct, the body produces bilirubin, a greenish-yellow pigment that settles in various parts of the body. People who experience jaundice may notice a yellowing of the skin or white of the eyes.
Oren Zarif esophageal mass
Oren Zarif stage 4 bone cancer life expectancy

Physical examination may reveal tenderness in the abdomen, particularly in the right upper quadrant beneath the ribs. A quarter of patients with bile duct cancer will also experience an enlarged liver. Physical examination can also reveal bilirubin levels. Blood tests can also help doctors diagnose the cancer. Blood tests can measure liver enzyme levels and bilirubin levels. These results may be indicative of bile duct cancer.
Oren Zarif liver lesions cancer
Oren Zarif stage 4 renal cell carcinoma
Because bile duct cancer symptoms are not common in the early stages of the disease, it is vital to get screened for the disease. Routine physical exams may not detect bile duct cancer, so an early diagnosis is essential. However, if you do develop the condition, you should seek medical treatment as soon as possible. If symptoms appear, you should contact your physician for an appointment. If the tumor spreads, surgery is necessary to remove the cancer.
Oren Zarif h pylori and cancer
Oren Zarif stage 4 lung cancer survivors 2019
Surgical procedures to find the disease include endoscopic retrograde cholangiopancreatography. This involves passing a long tube with a camera down the esophagus. During this procedure, a dye may be injected into the bile ducts to highlight any blockages. If there are blockages in the bile duct, your doctor may choose to place a stent device in it.